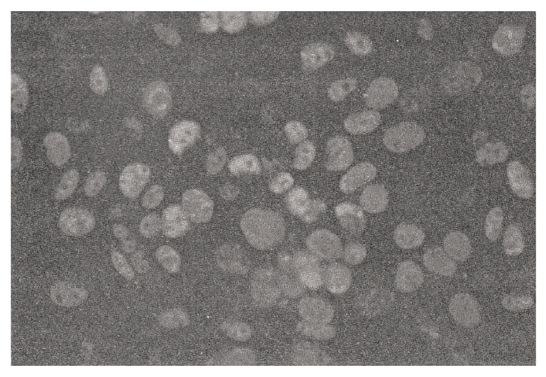

MOJ
eISSN: 2641-9297


Research Article Volume 1 Issue 2
International cancer prevention center, Japan
Correspondence: Tsuneo Kobayashi, International cancer prevention center, Chiba city, 3-21-1, Takasu, Mihamaku, Chiba city 261-0004, Japan, Tel 043-306-2611, Fax 043-279-4211
Received: June 01, 2017 | Published: April 30, 2018
Citation: Kobayashi Tsuneo. Given the continuing dispute over the role of genetic abnormalities and protracted mitochondrial respiratory dysfunction in carcinogenesis, what is the core underlying entity?. MOJ Curr Res & Rev. 2018;1(2):86-100. DOI: 10.15406/mojcrr.2018.01.00014
Background: For a long time, oncologists have believed that the main factors underlying carcinogenesis are related to genetic abnormalities or protracted mitochondrial respiratory dysfunction, which are core reasons for carcinogenesis. Thus, I want to discuss how to intend to demonstrate that mitochondria respiratory dysfunction might be the true causal factor underlying carcinogenesis by presenting evidence obtained in experiment in which specific herbal medicines are used to inhibit the oxygen respiration of cancer cells and cancer re-differentiation-inducing treatment is exploited to return cancer cells to normal cells.
Methods:
First project: I have discovered a specific herbal medicine that selectively affects cancer mitochondrial respiration function, and if this herbal medicine has an impact on the hallmarks of cancer, then the results would demonstrate that carcinogenesis originates from mitochondrial respiratory dysfunction.
Second project: I exploited cancer re-differentiation-inducing treatment developed 5 years ago.
So I could noninvasively treat cancer patients. This treatment was highly successful and didn’t require chemotherapy and radiotherapy.
Results: The herbal medicine (Sun Advance) had an impact on most of the hallmarks of the cancer in basic medical experiments. Furthermore, successful results were obtained for cancer patient treated with the re-differentiation-inducing treatment.
Conclusion: Carcinogenesis is a form of mitochondrial respiratory dysfunction. Therefore, primary cancer prevention and recurrence prevention programs should advocate for life-style changes and re-differentiation inducing treatment.
Keywords: Summation of genetic abnormalities, protracted mitochondrial respiratory dysfunction, genetic instability, herbal medicine specifically to inhibit cancer cell respiration, defective immune-surveillance, re-differentiation-inducing treatment
Sixty years ago, Otto Warburg initially proposed that aerobic glucose fermentation was an epiphenomenon representing one of the most fundamental problems in cancer cell physiology1 that is impaired or damaged respiratory dysfunction. But many oncologists believe that carcinogenesis originates because of a number of genetic abnormalities. Sidney Weinhouse 2,3 and Alan Aisenburg4 have criticized Warburg’s opinion. Although, Peter Pedersen5 and Thomas Seyfried et al.6 have shown that protracted mitochondrial respiratory dysfunction is the main reason for underlying carcinogenesis.6 However, much of the confusion surrounding the origin of cancer arises from absence of a unifying theory that can integrate the diverse observation on the nature of the disease.7 Thomas N Seyfried6 showed that the majority of cancer gene defects could arise as downstream epiphenomenon of tumor progression, rather than as cancer causes.6 Although almost 700 targeted therapies have been developed from cancer genome projects, a cure for patients with solid tumors, has not been developed based on these strategies.8 James Watson, the Novel Prizer who discovered double stranded DNA, recently suggested that more attention should be paid to the metabolism of cancer.9 Damage to mitochondria which causes a loss of cytochrome C from the associated mitochondria, is understood to which subsequently lose the ability to undergo apoptosis. Hybridization experiments have confirmed that normal mitochondria have the ability to overwhelm cancer mitochondria.
Koura H,10 Israel BA & Schaffer WI11 experimented with the hybridization of enucleated normal cells with cancer cells and they showed that the hybridized cell (cybrids) reverted to normal cells because the power of normal mitochondria were sufficiently powerful to overtake the nuclear DNA of cancer cells. Researchers who insist that carcinogenesis is induced by the accumulation of genetic abnormalities have neglected the results of these hybrids (cybrids) experiments as described bellow (Figure 1).10‒12 Thomas N Seyfried6 reported that normal mitochondria functions maintains a differentiated state, thereby suppressing carcinogenesis, whereas dysfunctional mitochondria can enhance dedifferentiation, thereby facilitating carcinogenesis.13–16 However, I believe that mitochondria involved in not only metabolic diseases, but also development diseases because mitochondria play a key role in cell differentiation.17,18 Sesaki H et al.18 have reported the direct proof that is from matured mitochondria changed to degraded or fragmented mitochondria by oncogenic MAPK signaling, vice versa, from fragmented mitochondria to matured mitochondria by oncogenic MAPK signaling inhibition.19 Many researchers have intensively studied cancer and reported that it is induced by nuclear DNA or mitochondria dysfunction and these findings are inconsistent as the results of Thomas Seyfried20 who reported the correlation between the oncogenic paradox and Warburg effect (Figure 2). These authors reported that carcinogenesis is a protracted form of mitochondrial dysfunction and indicated that genome abnormality occurs as down-stream of mitochondrial degradation. Based on my studies, I believe that this conclusion might also be true from my study. I have found a specific herbal medicine, Sun Advance (IMHC, Chiba city, Japan) although it is a mixture of 18 herbs. I have investigated their molecular basis for 10 years, nevertheless, I could not found any molecular basis, but, in this time, I made my mind that I manipulated it as a single medicine in further scientific research on this herbal medicine. This herbal medicine selectively inhibits oxygen consumption on Ehrlich ascites cancer cells.


First project: I hypothesized that this herbal medicine could be used to demonstrate that mitochondrial respiratory dysfunction is in reverse the true mechanism underlying carcinogenesis. Many researchers have investigated carcinogenesis based on carcinogenic factors and molecular changes caused by carcinogenesis. However, mitochondria function is closely related to molecular differentiation and morphological differentiation, a number of paradoxical reports has been published. Therefore, I intend to demonstrate that mitochondria respiratory dysfunction might be the true causal factor by utilizing Sun Advance which selectively inhibits the oxygen respiration of cancer cells, and I further intend to show how this herbal medicine (SA) affects the hallmarks of cancer.
Second project: I will attempt to differentiate the damaged dysfunctional mitochondria of cancer cells into normal cell by exploiting re-differentiation-inducing treatment (re-DIT). First, I want to demonstrate the current concept of mitochondria. Although in junior high school textbook, the cocoon-type of mitochondria in cells is shown as dead mitochondria. But our present understanding of organelle is outlined below. Mitochondria represent a dynamic energy delivery tubule network in the cell (Figure 3). However, mitochondria are not only energy centers, but also respiratory centers and differentiation centers. Mitochondria evolved over 1.8 billion years ago, and thus allowing anaerobic cells to evolve into aerobic higher energy eukaryotes that produce 38 ATP. Ninety percent of mitochondrial DNA was inserted into nuclear DNA, and only 10% of mitochondrial DNA remained in mitochondria by unknown reason. Mitochondria are fundamentally bacterial in origin; therefore, the fusion and fission of molecules occurs easily among mitochondria,16 which is a completely different process from eukaryote DNA mitotic cell division. Fertilization in higher animals between an egg and sperm may represent the process when original mitochondria entered into large anaerobic bacterial cell 1.8 billion year ago. Based on this line of thinking, hybridization experiments (cybrids) between enucleated normal cells and cancer cells should be considered as one type of fertilization.

Based on these data, the combination of SA, palmitate (FFA: P) and albumin or α-, or β-globulin co-operatively inhibited the oxygen consumption of Ehrlich ascites cancer cells. Over the short functioning term of 30 minutes, it means perhaps this inhibition may have represented a direct effect of the SA with serum fraction and palmitate on damaged mitochondria. Moreover, normal cells were not affected at all, as shown below. Thus, the observed inhibiting effects were a selective reaction to Ehrlich ascites cells. Here, the effects on normal cells (C3H, mouse kidney cell) of applying the SA are showed below (Figure 9). Ex shows the extracted juice of apple and cucumber.

Figure 4 Effect of SA( 35μg)(Ⓢ) and human albumin (10-4 M)(A) + FFA ( palmitate 10-5M)(P) on Ehrlich ascites tumor cells( 109cells). Each sample includes 10 samples tested and data are averaged. Ehrlich ascites cell are cultured in the incubator at 37°C. Oxygen respiration of Ehrlich as cites cancer was stopped 30minutes after the addition of 35μg SA.


Figure 6 Interaction of SA (Ⓢ) and α-globulin-FFA (αP) in oxygen uptake of Ehrlich ascites tumor cells. α-globulin (0.15%)(α), palmitate( 2x10-3M)(P) and SA(Ⓢ)(35μg) were utilized. SA (.Ex) means which was mixture of SA and mix-juice of apple and cucumber. Ehrlich ascites cell are cultured in the incubator at 37°C. Oxygen respiration was stopped 30 minutes after the addition of 35μg SA.

Figure 7 Effect of SA + β-globulin + palmitate (2x104M) on respiration of Ehrlich ascites tumor cells. β-globulin ( 0.4%), palmitate( 2x104 M), SA(Ex: 50/ 50) Ehrlich ascites cell are cultured in the incubator at 37°C. Oxygen respiration was stopped 30 minutes after the addition of 35μg SA.

Figure 8 Interaction of SA (Ex: 35μg), γ–globulin ( 0.4%) and palmitate( 2x10-3M) in Ehrlich ascites tumor cells, are tested by Warburg oxygen consumption meter. Ehrlich ascites cell are cultured in the incubator at 37°C. Oxygen respiration was not stopped with the collaboration with γ-globulin.

Each topic will be demonstrated stepwise.


Figure 11 Inhibitory effect of Sun Advance on metastasis. 5x106 of MH134 cells were injected sc in tails of syngeneic C3H mice. Mice were given SA (B: 4.2mg or C: 0.9mg/ml) per os from day 0 after the injection to day 14. The number of mice with metastatic lymph nodes was counted on day 14 by autopsy examination.



Figure 14 Inhibiting effect of SA on SV40-transformation of mouse cells without SA.C3H mouse kidney cells (103) were seeded on one plate in the absence of 35μg/ml of SA and infected with SV40 virus ( 106PFU/0.2ml). Aggregation and pile up are observed.

Figure 15 Effect of SA on inhibiting SV40-transformation of mouse cells with SA. C3 H mouse kidney cells (103) were seeded on one plate in the presence of 35μg/ml of SA and infected with SV40 virus (106PFU/0.2ml). Black spot are there, but no transformation observed.

Figure 16 Microscopic observations of the black sites under high magnification. Mouse kidney cells (103) were seeded in the absence (left side) and presence (right side) of SA( 35μg/ml). SV40 virus (3.5 x 106PFU) was infected. They were grown up for 14 days. There is confirmatively cell to cell contact inhibition on the right side photograph in comparison with left side photograph which showed transformation and aggregation.

Figure 17 Inhibition of SV40 virus-transformation by SA. Mouse kidney cells (103) were treated with SV40 virus (107PFU/0.2ml) or Hanks’ BSS in the presence (+) or absence (-). And 1.5 x 104cells/ dish were seeded in the low calcium medium on day 1. SA (35μg) was subsequently added as shown black bar. Foci were scored on day 4 or 21.
Figure 19 Fluorescent colors was admitted when T-antigen was produced When SV40 virus was infected on CV1 cell and viral DNA is incorporated into nuclear DNA, T-antigen will be produced on the cell surface. SV40 virus (3.5 x 104PFU) 0.1ml was cultured on monolayer of CV1 cell with SA( 35μg/ml) 1.4ml of tissue culture solution was added. Day 5 and 10, coverslip was washed with PBS and fixed with acetone for 10 minutes. Anti-SV40 T serum ( cancer borne hamster serum 1:20) 0.1ml was incubated for 25 minutes at 37°C. After washing with PBS, stained with anti-Hamster-γ-FITC (1:15, Sanko―Junyaku) and washed with PBS and D2W and enclosed with 90% glycerol.

Figure 20 Dose response relationship for the action of SA-Ex on SV40-transformed mouse kidney cells.
3 x 103cells/ dish, sub-cultured from a SV40 transformed colony in the low Ca 2+ medium, were seeded and treated with SA-Ex which was the combination of SA and apple and cucumber juice (50/50), on day 3. Colonies were counted on day 10. The number of colonies without SA-Ex was 190.

Second project
We applied this treatment on a recurred patient (48 years old male) who suffered from the recurrence of Leiomyosarcoma as pathological diagnosis on the upper right hand. After surgical resection (27, May, 2015), the sarcoma metastasized to the lung in September, 2015. Chemotherapy was performed with doxorubisin (126mg), but it did not disappear by December, 2015. Therefore, the patient presented at my hospital, and he subsequently received the cancer re-differentiation-inducing treatment (Figure 36). Left photograph shows a CT at September, 2015, center and right photograph show the CT at January, 2016. As shown in CT image, metastases have clearly disappeared after January 2016 (Table 1). The patient’s initial risk assessment according to the TMCA was classified as tumor stage V (=G2), whereas, in July 2017, the TMCA risk assessment was classified as TS (III). There is no relapse of recurrence for 2 years after he received re-differentiation inducing treatment.

Figure 22 Reitzer et al.42 has demonstrated that the concentration of ATP in Hela cells incubated in the absence of sugar with or without oxygen. Cells were pregrown in Minimum Essential Medium Joklik, 5% nondialyzed fetal calf serum spinner cultures, which support exponential growth to 106cells/ml. At 3x105cells/ ml, 200ml was centrifuged at 1500g for 15min at room temperature and immediately re-suspended in 10ml of Minimum Essential Medium Jolik containing 20mM 4-(2-hydroxyethyl)-L-piperazine-ethane-sulfonic acid, pH 7, without serum or glucose. The medium used for the anaerobic incubation had been deoxygenated by bubbling 100% N2 though it for at least 10min. the cells were re-suspended gently to avoid oxygenating the medium and the gassing continued above the medium during the incubation. The aerobic culture was exposed to the atmosphere. The flasks were shaken rapidly in a water bath at 37°C. At the indicted times, 1.5ml of culture was mixed with 0.25ml of 2.4N HClO4 with 8mM EDTA at 0°C.,and centrifuged at 12,006g for 20min. The supernatant was neutralized with KOH, using the phenol red indictor present in the medium, and after removing potassium perchlorate by centrifugation, ATP was measured as described.42


Figure 25 Adoptive lymphocytes therapy on advanced cancer patients Lymphocytes was gotten from 100ml of donor’s blood by centrifugation method utilizing Lymphoprep ® and suspended in physiological serine and made suspension of 1~2 x 108/ml SI is stimulation index by PHA. So as to release cancer antigen from cancer tissue, we have manipulated cancer patients utilizing the combination of vitamin A (5x104U) and sauna bathing at 56°C. For 20 minutes. Adoptive lymphocytes were infused after 24~30 hours inducing cancer antigen treatment.

Figure 26 Lymphocyte adoptive immunotherapy treatment’s schedules. So as to release cancer antigen from cancer tissue, we have manipulated cancer patients utilizing the combination of vitamin A (retinoic acid: 5x104 U) and sauna bathing at 56°C for 20 minutes. Adoptive lymphocytes were infused after 24~30hours inducing cancer antigen treatment.

Figure 27 These experiments were carried out by the schedule of 2. Adoptive lymphocytes (1~2 x108 ml) therapy, so as to release cancer antigen from cancer tissue, we have manipulated cancer patients utilizing the combination of vitamin A (retinoic acid: 5x104 U) and sauna bathing at 56°C for 20 minutes. Adoptive lymphocytes were infused after 24~30 hours inducing cancer antigen treatment.








Time course |
14.Jan.2016 |
14.Jan.2016 |
18.Feb.2016 |
17.Mar.2016 |
19.Apr.2016 |
13.Jun.2016 |
Ferritin (FT) |
489 |
337 |
186 |
225 |
195 |
208 |
Serum iron(Fe) |
75 |
67 |
46 |
78 |
71 |
85 |
FT/Fe |
6.5 |
5 |
4 |
2.8 |
2.7 |
2.4 |
Thymidine |
59.1 |
5.9 |
2.1 |
3.6 |
3.1 |
4.5 |
Kinase (TK) α1-globulin |
3 |
2.6 |
2.6 |
2.4 |
2.4 |
2.4 |
Albumin |
60.7 |
60.4 |
62.3 |
60.7 |
60.2 |
61.1 |
Risk assessment |
TS(V)(G2) |
TS(IV) |
TS(IV) |
TS(III) |
TS(III) |
TS(III) |
CT exam. |
Meta (+) |
(-) |
|
|
(-) |
|
Table 1 Proceeding of metastasized Leiomyosarcoma patient (48 years old male) in the lung who was followed by various tumor marker
The second case study shows that 30 years old female woman suffered from undifferentiated ovarium cancer and her pathological diagnosis was undifferentiated germinoma. She received resection of the ovarium twice. After resection, she underwent chemotherapy 4 times. Subsequently she presented at my hospital and underwent tumor marker-inducing examination utilizing a combination of vitamin A and hyperthermia.46,47 The following data were recorded: CEA: 2.2ng, ΔCEA which means the width of changing data during 48hours; 1.0μg), Ferritin(FT);160μg(ΔFT: 40μg), FT/ Fe=2.2, ΔFT/Fe=0.6, LDH: 294 (ΔLDH=41U), Ribonuclease (202 U), α1-golbulin:3.5%, Albumin (64%), T cell number (1468), stimulation index (173), and NK cell activity (17.8%) I have diagnosed her condition as TS (V): gram level cancer: G2 (clinical level): cancer stage II according to cancer risk assessment method by TMCA which was reported in cancer.29 Then, she underwent a PET examination, which revealed a right side Virchow lymph-node metastasis. The patient subsequently received SA by oral intake and detoxifying refreshment treatment and dietary energy restriction for 6 months and the clinical findings indicated that she had improved into normal range showed below Table 2. The patient was followed for 18 years later and her cancer has not recurred. Patient’s TMCA data are currently as follows: Thymidine kinase: 7.7, α1-globulin fraction (2.6%), Albumin (61.1%), LDH (238). In addition, her present risk assessment was classified into TS (III). In her case, there is no relapse at all for 18 years. We applied this type of treatment for 30 cancer patients and success was observed in 70% among these patients, most of them are no recurrence.
Date |
Oct.(1999) |
July(2000) |
Jan.(2001) |
Feb.(2002) |
Jan.(2005) |
July(2015) |
RNase |
202U |
147 |
111 |
99 |
99 |
- |
Thymidine kinase |
- |
- |
- |
- |
- |
7.7 |
Albumin |
64% |
67.4 |
65.1 |
65.2 |
62.9 |
61.1 |
α1-globulin |
3.50% |
2.9 |
3 |
2.9 |
2.9 |
2.6 |
NK activity |
17.80% |
24 |
- |
66 |
- |
- |
Risk assessment |
TS(Ⅴ)(G2) |
TS(Ⅴ)(G1) |
TS(Ⅳ) |
TS(Ⅳ) |
TS(Ⅳ) |
TS(Ⅲ) |
Table 2 The proceeding of undifferentiated ovarium cancer (30 years old female)
I presented the results of 2 projects. The first project utilized SA, which is a specific herbal medicine, which selectively inhibit the oxygen respiration of cancer cells at tissue culture level and animal experiment level. The findings indicated that most of the hallmarks of cancer were inhibited by SA, thus, this treatment is feasible for use. These data may demonstrate that mitochondrial respiratory dysfunction is the underlying entity in carcinogenesis and no correlation of primary DNA abnormality on carcinogenesis. The second project showed that the potential applicability of a re-differentiation-inducing treatment for damaged mitochondria, and the success of cancer re-differentiation inducing treatment showed that mitochondrial respiratory dysfunction would be the factor underlying of carcinogenesis. Cancer is not only a mitochondrial respiratory disease but also a developmental disease because mitochondria are deeply connected to cell differentiation. Thus, the transformation of cancer cells to immortal cells is a change on the sovereignty in the form of respiration from a higher energy production system (mitochondrial oxygen respiration) to an older type of bacterial fermentation system. Therefore, I have demonstrated that cancer is a reversible disease and not immortal disease caused by gene abnormalities, and it can be treated by restoring the protracted mitochondrial dysfunction via the 2 treatments described herein. Moreover, TMCA should be applied during integrative medical evaluations.29
There are a great discrepancy between microscopic study and macroscopic study as yet. We have researched frontally on this problem. Many carcinogenic research of herbal medicine suggested indirectly that carcinogenesis induced ghost like change of mitochondria up to now, but my research of herbal medicine (SA) inversely showed for the first time that the inhibition of mitochondria degradation leads to the inhibition of carcinogenesis on the Thomas Seyfried’s5 Figure 2. We have reported that core reason of carcinogenesis is depended upon the ghost like change or degradation and segregation of mitochondria according to Koch’s rule. Sesaki Hiromi et al.19 proved that matured mitochondria changed to fragmented mitochondria by the oncogenic MAPK signaling and showed cancer metabolism, on the other hand, oncogenic MAPK signaling inhibition changed from fragmented mitochondria to matured mitochondria. Furthermore, Japanese and American researcher’s group showed that anti-oncogene works for the evolution of multicellularity. On the other hand, the destruction of oxygen respiration system in mitochondria should be considered an underlying cause for carcinogenesis because dedifferentiation produced reverting changes in the mitochondria shape and cristae, looking like procedure of reprograming because the Novel Prizer, Yamanaka Shinya of induced pluripotent stem (iPS) cell formation requires 3 gene and 1 c-myc gene and this c-myc is onco-gene which is requisite as Yamanaka factors.31
Fundamentally, energy production system is infrastructure of cellular life. So infrastructure of energy production system changed from high energy eukaryotic energy system to bacterial low energy system is more important reason of changing of cellular division system than genetic changing. As the molecular biologist explained that apoptosis become difficult after cytochrome C and calcium leaked out from mitochondria, nevertheless, this phenomenon has a possibility of secondary event from Sesaki Hiromi et al.19 report and from my data. As we could not directly proved that herbal medicine (SA) let change morphological evidence of mitochondria, but herbal medicine SA has strong effect on lipid metabolism and because mitochondria is mainly composed of cardiolipin which paved the inner mitochondria membrane of cancer cell.48 From immunological standpoint, the relationship between PD-1 and PD-L1 are intimately correlated with mitochondria function. Honjo Tasuku et al.49 reported that there is intimate correlation with mitochondria function and PD-1 receptor.49 PD-1 blockade shows that immune activity has a possibility of intimate correlation with mitochondria function.
As ATP is generated only in mitochondria, degradation of mitochondria according to the carcinogenesis and consecutively lowering serum content of cyclic AMP is reasonable and the phenomenon of defective immune-surveillance in cancer patients is also reasonable because of lowering concentration of seral cyclic AMP. Cyclic AMP is the same molecule with ATP, but energy level is different, 2 kilocalorie (12Kcal) higher than ATP (10Kcal) which was said by my Professor Hayaishi Osamu who is the founder of oxygenase. This may be the reason why a small amount of 1mM cyclic AMP has strong re-differentiation activity on cancer cell and this phenomenon has not primary correlation with genetic change. Herbal medicine (SA) showed that most of carcinogenesis is reversible. Therefore, we have exploited re-differentiation inducing treatment. On the concluding remark, we have tried re-differentiation inducing treatment of mitochondria on cancer patients. Getting our good clinical results, our way of thinking may be right. We have pointed out the puzzle for the first time why 90 % of mitochondrial DNA exists in nuclear DNA and 10 % of mitochondrial DNA locate in mitochondria. Recently we have found that one of ingredients of herbal medicine (SA) include much of cyclic AMP. But it is impossible for us to reveal all the molecular basis of herbal medicine (SA) as yet. As the way of thinking in western medicine which would be hesitating to single substances, but, life phenomenon is usually depending upon complex system, for example DNA replication is depend upon 4 base substances, cytidine, thymidine, adenine and guanine, likewise, the effect of herbal medicine (SA) which is not known the molecular basis, nevertheless, important thing is experimental reproducibility from scientific position, we should not neglected the reproducing evidence of herbal medicine (SA) even if without molecular basis.
I would express sincere gratitude to Dr Thomas Seyfried, Koura M, Professor Shigeru Arichi, and many researchers whom I have cited in this paper. I am also grateful to my assistants: Tanimizu Tomoko, Sugimoto Kimito, Hayashi Nobuko, Miura Miyoko, Hosoya Kuniko, Maki Akiko, Kijima Chizuko, Jo Tokio, Ozaki Hoshiko, Harumiya Satoru and Suzuki Hideaki.
The author declares that there is no conflict of interest.

©2018 Kobayashi. This is an open access article distributed under the terms of the, which permits unrestricted use, distribution, and build upon your work non-commercially.